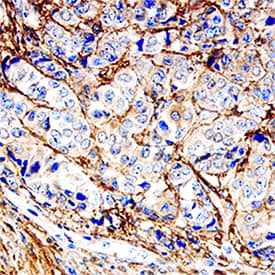
Decorin antibody in Human Breast by Immunohistochemistry (IHC-P).

Human Decorin Antibody
R&D Systems, part of Bio-Techne | Catalog # AF143


Key Product Details
Species Reactivity
Validated:
Cited:
Applications
Validated:
Cited:
Label
Antibody Source
Product Specifications
Immunogen
Gly17-Lys359
Accession # P07585
Specificity
Clonality
Host
Isotype
Scientific Data Images for Human Decorin Antibody
Detection of Human Decorin by Western Blot.
Western blot shows lysates of human uterus tissue and human heart tissue. PVDF membrane was probed with 0.1 µg/mL of Goat Anti-Human Decorin Antigen Affinity-purified Polyclonal Antibody (Catalog # AF143) followed by HRP-conjugated Anti-Goat IgG Secondary Antibody (HAF017). A specific band was detected for Decorin at approximately 100 kDa (as indicated). This experiment was conducted under reducing conditions and using Immunoblot Buffer Group 1.Decorin in Human Breast.
Decorin was detected in immersion fixed paraffin-embedded sections of human breast using Goat Anti-Human Decorin Antigen Affinity-purified Polyclonal Antibody (Catalog # AF143) at 15 µg/mL overnight at 4 °C. Tissue was stained using the Anti-Goat HRP-DAB Cell & Tissue Staining Kit (brown; (CTS008) and counterstained with hematoxylin (blue). Specific staining was localized to intralobular stromal tissue. View our protocol for Chromogenic IHC Staining of Paraffin-embedded Tissue Sections.Detection of Human Decorin by Simple WesternTM.
Simple Western lane view shows lysates of human uterus and human heart tissue, loaded at 0.2 mg/mL. A specific band was detected for Decorin at approximately 140-149 kDa (as indicated) using 5 µg/mL of Goat Anti-Human Decorin Antigen Affinity-purified Polyclonal Antibody (Catalog # AF143) . This experiment was conducted under reducing conditions and using the 12-230 kDa separation system.Applications for Human Decorin Antibody
Immunohistochemistry
Sample: Immersion fixed paraffin-embedded sections of human breast
Simple Western
Sample: Human uterus tissue and human heart tissue
Western Blot
Sample: Human uterus tissue and human heart tissue
Formulation, Preparation, and Storage
Purification
Reconstitution
Formulation
Shipping
Stability & Storage
- 12 months from date of receipt, -20 to -70 °C as supplied.
- 1 month, 2 to 8 °C under sterile conditions after reconstitution.
- 6 months, -20 to -70 °C under sterile conditions after reconstitution.
Background: Decorin
Decorin is a small secreted chondroitin/dermatan sulfate proteoglycan in the family of small leucine-rich proteoglycans (SLRPs). SLRP family members are characterized by N-terminal and C-terminal cysteine-rich regions which flank the central region containing 10‑12 tandem leucine-rich repeats (LRR) (1, 2). The human Decorin cDNA encodes a 359 amino acid (aa) precursor that includes a 16 aa signal sequence and a 14 aa propeptide. The 329 aa mature protein contains twelve LRR. Alternate splicing generates five isoforms with variable length deletions (3). Mature human and mouse Decorin share 80% aa sequence identity. In Decorin, serine 34 in the N-terminal domain is O-glycosylated. Naturally occurring Decorin proteoglycan has a molecular mass of approximately 100 kDa, and the deglycosylated Decorin core protein has a mass of approximately 40 kDa. Decorin binds to fibronectin, TGF-beta, and type I and type II collagens. The binding of Decorin to various molecules was reported to be mediated via the core protein. Decorin has been implicated in matrix assembly and has also been reported to suppress the growth of various tumor cell lines by activating the epidermal growth factor receptor.
References
- Naito, Z. (2005) J. Nippon Med. Sch. 72:137.
- Matsushima, N. et al. (2005) Cell. Mol. Life Sci. 62:2771.
- Danielson, K. et al. (1993) Genomics 15:146.
Alternate Names
Gene Symbol
UniProt
Additional Decorin Products
Product Documents for Human Decorin Antibody
Product Specific Notices for Human Decorin Antibody
For research use only